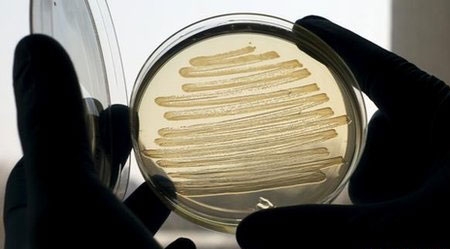

Tập huấn bồi dưỡng kiến thức quốc phòng – an ninh cho phóng viên, biên tập viên và đội ngũ luật sư
Trong ba ngày, từ 20 đến 22-8 tại Bộ Chỉ huy Quân sự tỉnh, Hội đồng giáo dục Quốc phòng – An ninh tỉnh đã tổ chức lớp bồi dưỡng kiến thức quốc...
14 năm trước 2,370 lượt xem
Tôm om riềng đưa cơm ngày mát trời
Với món tôm rim riềng, chỉ cần chưa đến 30 phút là bạn đã có một món mặn thơm ngon cho cả nhà!
14 năm trước 1,518 lượt xem
Khai mạc khóa họp lần thứ 67 Đại hội đồng LHQ
Chiều 18/9 (theo giờ địa phương – sáng 19/9 giờ Hà Nội), tại trụ sở chính ở thành phố New York (Mỹ), Đại hội đồng LHQ khóa 67 đã chính thức khai mạc, với...
14 năm trước 1,415 lượt xem
Vai trò lãnh đạo của một Đảng bộ doanh nghiệp tư nhân trong suy thoái kinh tế
Trong bối cảnh gần một nửa số doanh nghiệp hoạt động cầm chừng, một số giải thể, chuyển nhượng, Công ty TNHH Sứ Đông Lâm là một trong rất ít...
14 năm trước 1,591 lượt xem
Đổi mới căn bản, toàn diện giáo dục phổ thông - Góc nhìn từ cơ sở
Sau hơn 25 năm tiến hành công cuộc đổi mới, giáo dục phổ thông nói riêng, GD và ĐT nói chung đã giành đựơc nhiều thành tựu quan trọng cả về phát triển quy...
14 năm trước 1,671 lượt xem
Về nơi đánh thức tâm hồn đá
Nói đến các làng nghề độc đáo và phát triển mạnh hiện nay ở Miền Trung, mà không nhắc tới Làng đá mỹ nghệ Non Nước, Thành phố Đà Nẵng, là một thiếu...
14 năm trước 941 lượt xem
Thường trực HĐND tỉnh Giám sát tình hình kinh tế - chính trị xã hội tại Vũ Thư
Chiều 23-11-2012, đồng chí Đặng Xuân Thiều - Uỷ viên BTV Tỉnh uỷ, Phó Chủ tịch HĐND tỉnh cùng đoàn công tác của Thường trực HĐND tỉnh đã tiến hành...
14 năm trước 1,496 lượt xem
Đại hội đại biểu Công đoàn ngành NN&PTNT
Sáng ngày 06/12/2012, Đại hội đại biểu Công đoàn ngành NN&PTNT Thái Bình chính thức khai mạc với sự tham dự của 150 đại biểu đại diện cho trên 2.000 cán...
14 năm trước 1,202 lượt xem
Nhật Bản tiếp tục nới lỏng tiền tệ
Ngày 20/12, Ngân hàng Trung ương Nhật Bản (BOJ) quyết định tiếp tục thực thi chính sách nới lỏng tiền tệ nhằm vực dậy nền kinh tế của nước này.
14 năm trước 1,382 lượt xem
Những nẻo đường hòa bình tới Hiệp định Paris
Dù đã 40 năm, nhưng hình ảnh các đoàn đàm phán Việt nam vẫn in đậm trong ký ức những nhân chứng và thế hệ sau.
13 năm trước 4,651 lượt xem
Ngành Thuế Tiền Hải Những kỳ vọng vào năm mới
Khép lại năm 2012, ngành Thuế Tiền Hải đạt tổng thu trên 131,701 tỷ đồng. Mặc dù đạt 128% so với dự toán pháp lệnh và bằng 103% dự toán phấn đấu,...
13 năm trước 1,819 lượt xem
Bổ sung 500.000 euro phát triển cụm doanh nghiệp nhỏ và vừa
Đây là vốn viện trợ không hoàn lại của UNIDO cho dự án phát triển cụm doanh nghiệp nhỏ và vừa của Việt Nam.
13 năm trước 1,218 lượt xem
Nga: Kỷ niệm 70 năm chiến thắng lịch sử Stalingrad
Ngày 31/1, Thành phố anh hùng Volgograd - tên gọi trước đây là Stalingrad, bắt đầu những hoạt động kỷ niệm 70 năm chiến thắng lịch sử Stalingrad...
13 năm trước 1,096 lượt xem
Tết “hội nhập”
Một năm nữa lại đã qua, cầu chúc cho mọi người bình an và may mắn trong năm mới. Cầu mong một ngày đất nước đi lên để mỗi năm Tết đến xuân về...
13 năm trước 1,977 lượt xem
Chủ tịch Hồ Chí Minh với công tác giáo dục, bồi dưỡng thế hệ trẻ
Chuyên đề học tập và làm theo tấm gương đạo đức Hồ Chí Minh phục vụ sinh hoạt chi bộ cơ sở tháng 3 năm 2013
13 năm trước 2,917 lượt xem
Phó Chủ tịch nước Nguyễn Thị Doan Gặp mặt các đại biểu dự diễn đàn đa chiều “Xóa đói giảm nghèo và tăng trưởng bền vững”
Chiều ngày 6/3, tại Phủ Chủ tịch, đồng chí Nguyễn Thị Doan, Ủy viên Trung ương Đảng, Phó Chủ tịch nước đã gặp mặt thân mật với 50 doanh nhân tiêu biểu và...
13 năm trước 1,568 lượt xem
Ngược dòng đánh bại Del Potro, Nadal vô địch Indian Wells 2013
Rafael Nadal đã trở lại đầy ấn tượng khi vừa ngược dòng đánh bại Del Potro 4-6, 6-3, 6-4 để doạt danh hiệu ATP thứ 53 trong sự nghiệp.
13 năm trước 1,062 lượt xem
Tạo chính sách bình đẳng cho lao động ở khu vực kinh tế phi chính thức
Để giải quyết việc làm, tạo công bằng trong xã hội là một trong những mục tiêu quan tâm của nhà nước ta. Tuy nhiên, để thực hiện được mục tiêu...
13 năm trước 1,853 lượt xem
Doanh nghiệp vận tải tính tăng giá cước 5 - 6%
Với quyết định tăng giá xăng dầu của liên bộ Tài chính - Công Thương vừa qua, nhiều doanh nghiệp (DN) vận tải đang tính sẽ tăng giá cước 5 - 6%.
13 năm trước 1,163 lượt xem
Ban Thường vụ Tỉnh ủy Nghe và cho ý kiến về kết quả tổ chức thực hiện việc lấy ý kiến hộ gia đình, cá nhân về Dự thảo sửa đổi Hiến pháp năm 1992
Chiều 17/4, Ban Thường vụ Tỉnh ủy họp dưới sự chủ trì của đồng chí Trần Cẩm Tú, Ủy viên Trung ương Đảng, Bí thư Tỉnh ủy nghe và cho ý kiến về kết quả tổ...
13 năm trước 1,369 lượt xem
Sản xuất dầu diesel từ vi khuẩn gây tiêu chảy
Các nhà nghiên cứu Anh đã biến đổi gen vi khuẩn E. coli - một trong những thủ phạm gây tiêu chảy ở người, để chuyển hóa đường thành một dạng nhiên...
13 năm trước 1,031 lượt xem
Những ngôi nhà siêu quái dị trên thế giới
Với ý tưởng phong phú, các kiến trúc sư đã sáng tạo ra những công trình nghệ thuật khiến nhiều người phải trầm trồ bởi nét độc đáo và dị...
13 năm trước 480 lượt xem
Bangladesh đóng cửa hàng trăm nhà máy may mặc
Bắt đầu từ ngày 14/5, hàng trăm nhà máy may mặc ở Bangladesh sẽ phải đóng cửa vô thời hạn sau khi xảy ra thảm họa sập nhà khiến hơn 1.100 công nhân...
13 năm trước 1,106 lượt xem
Sữa chua mít - đơn giản mà thú vị
Hãy thử tự làm những bát sữa chua mít dễ thương, ăn mát ruột đẹp da để đãi bạn bè, người thân mà chẳng cần ra hàng quán mua nhé.
13 năm trước 1,658 lượt xem
Chăm sóc mắt sau phẫu thuật đục thủy tinh thể
Rất nhiều bệnh nhân sau phẫu thuật đục thủy tinh thể không biết cách chăm sóc thế nào để giữ mắt sáng, tới khi có những biến đổi khó chịu (mi mắt bị phù,...
13 năm trước 1,599 lượt xem
Đông Hưng Đẩy mạnh công tác đấu tranh phòng, chống ma túy
Những năm qua công tác đấu tranh phòng, chống ma túy trên địa bàn huyện Đông Hưng được các cấp ủy, chính quyền và các ban, ngành, đoàn thể quan tâm thực...
13 năm trước 2,430 lượt xem
Ngày làm việc thứ 24, kỳ họp thứ năm, Quốc hội Khóa XIII Thảo luận về dự án Luật Thực hành tiết kiệm, chống lãng phí (sửa đổi)
Ngày 18-6, Kỳ họp thứ năm, Quốc hội (QH) khóa XIII, sang ngày làm việc thứ 24.
13 năm trước 1,016 lượt xem
Chương trình phối hợp vận động, hỗ trợ phụ nữ xây dựng gia đình hạnh phúc Những kết quả bước đầu
Chương trình phối hợp số 4646/CTPH-BVHTTDL-HLHPNVN giữa Bộ Văn hóa, Thể thao và Du lịch (VHTT và DL) và Hội Liên hiệp phụ nữ (LHPN) Việt Nam ngày...
13 năm trước 1,140 lượt xem
Nem chay vừa ngon vừa mát cho mùa hè
Bạn có thể cảm nhận ngay được sự thanh mát, chay tịnh của món nem phù trúc cuộn rau củ này.
13 năm trước 1,264 lượt xem
Hơn 400 vận động viên tham gia giải Wushu trẻ toàn quốc
Tối ngày 15/7 tại Nhà thi đấu Thể dục Thể thao tỉnh đã diễn ra lễ khai mạc Giải Wushu trẻ toàn quốc năm 2013. Giải do Tổng cục Thể dục Thể thao phối hợp...
13 năm trước 1,495 lượt xem